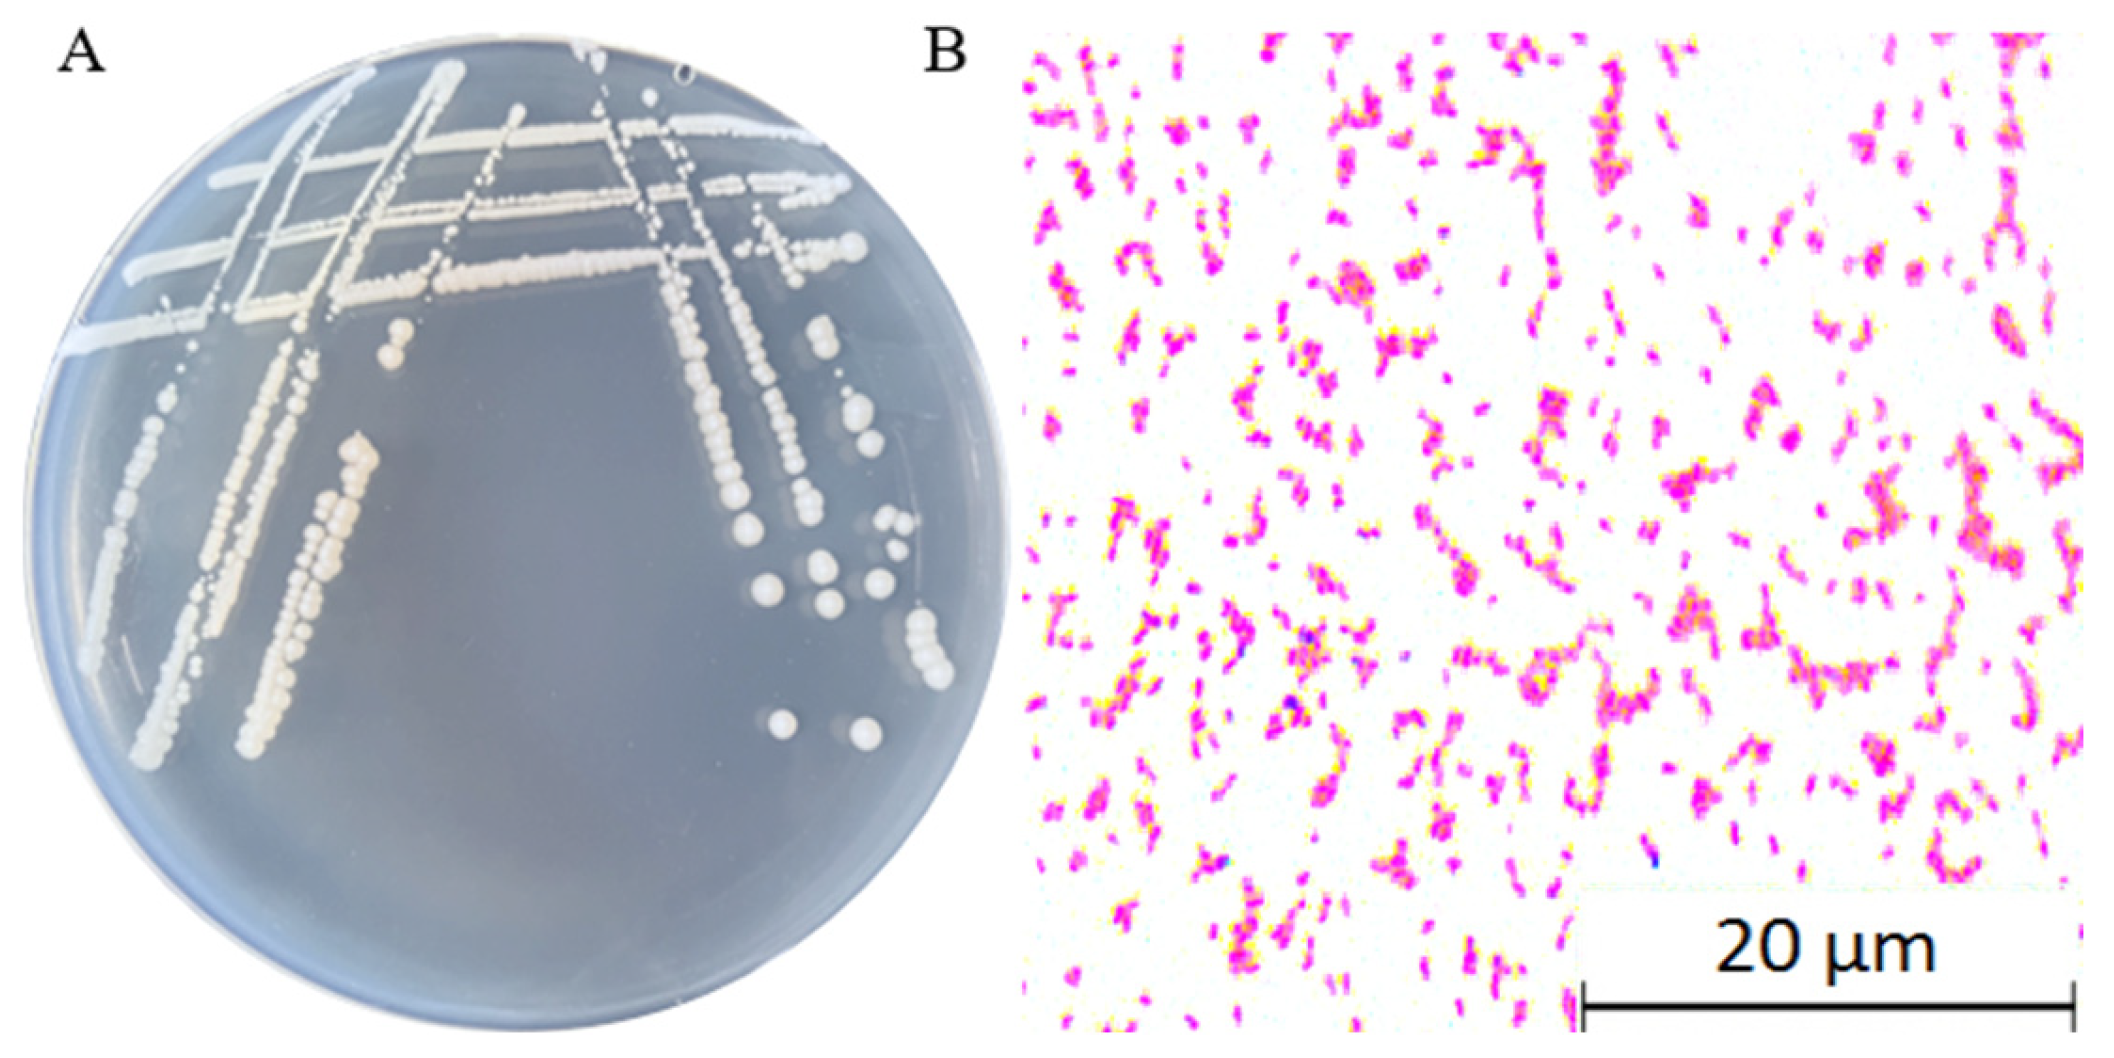

Whole-Genome Analysis and Growth-Promoting Mechanism of Klebsiella pneumoniae YMK25 from Maize Rhizobacteria
Abstract
1. Introduction
2. Results
2.1. YMK25 Exhibits Superior Nitrogen Fixation and Phosphate Solubilization
2.2. YMK25 Produced Siderophores at Excellent Expression Level
2.3. YMK25 Possesses a Robust IAA Production Capacity
2.4. Characterization of the Fundamental Physicochemical Properties of YMK25
2.5. Phylogenetic and Genomic Similarity Analysis
2.6. Whole Genome Characterization and Annotation of Strain YMK25
2.7. Prediction of Plant Growth-Promoting Genes in YMK25 Genome
2.8. YMK25 Possesses a Growth-Promoting Effect on Maize Seedlings
3. Discussion
3.1. In Vitro Evidence of YMK25’s Agricultural Potential
3.2. Genomic Insights and Functional Annotation
3.3. Application of YMK25 in Agriculture
4. Materials and Methods
4.1. Soil Samples and Strain Isolation
4.2. Assessments of Strain Promoting Properties In Vitro
4.3. Determination of Basic Physicochemical Properties of the Strain
4.4. Identification and Genomic Analysis of the Strain
4.5. Analysis of Strain-Induced Growth Promotion in Maize
4.6. Data Statistics and Analysis
5. Conclusions
Author Contributions
Funding
Conflicts of Interest
References
- Ma, G.Z.; Cheng, S.H.; He, W.L.; Dong, Y.X.; Qi, S.W.; Tu, N.M.; Tao, W.X.; Garcia, R. Effects of Organic and Inorganic Fertilizers on Soil Nutrient Conditions in Rice Fields with Varying Soil Fertility. Land 2024, 12, 1026. [Google Scholar] [CrossRef]
- Yang, S.; Liu, H.; Xie, P.; Wen, T.; Shen, Q.; Yuan, J. Emerging Pathways for Engineering the Rhizosphere Microbiome for Optimal Plant Health. J. Agric. Food Chem. 2023, 71, 4441–4449. [Google Scholar] [CrossRef] [PubMed]
- Khoso, M.A.; Wagan, S.; Alam, I.; Hussain, A.; Ali, Q.; Saha, S.; Poudel, T.R.; Manghwar, H.; Liu, F. Impact of Plant Growth-Promoting Rhizobacteria (PGPR) on Plant Nutrition and Root Characteristics: Current Perspective. Plant Stress 2024, 11, 100341. [Google Scholar] [CrossRef]
- Zhou, Y.F.; Bai, Y.S.; Yue, T.; Li, Q.W.; Huang, Y.N.; Jiang, W.; He, C.; Wang, J.B. Research Progress on the Growth-Promoting Characteristics of Plant Growth-Promoting Rhizobacteria. Microbiol. China 2023, 50, 644–666. [Google Scholar]
- Duca, D.R.; Glick, B.R. Indole-3-Acetic Acid Biosynthesis and Its Regulation in Plant-Associated Bacteria. Appl. Microbiol. Biotechnol. 2020, 104, 8607–8619. [Google Scholar] [CrossRef] [PubMed]
- Zhang, J.; Wei, L.; Yang, J.; Ahmed, W.; Wang, Y.; Fu, L.; Ji, G. Probiotic Consortia: Reshaping the Rhizospheric Microbiome and Its Role in Suppressing Root-Rot Disease of Panax Notoginseng. Front. Microbiol. 2020, 11, 701. [Google Scholar] [CrossRef]
- He, H.; Hu, Q.; Li, R.; Pan, X.; Huang, B.; He, Q. Regional Gap in Maize Production, Climate, and Resource Utilization in China. Field Crops Res. 2020, 254, 107830. [Google Scholar] [CrossRef]
- Luo, N.; Meng, Q.; Feng, P.; Qu, Z.; Yu, Y.; Liu, D.L.; Müller, C.; Wang, P. China Can Be Self-Sufficient in Maize Production by 2030 with Optimal Crop Management. Nat. Commun. 2023, 14, 2637. [Google Scholar] [CrossRef]
- Navarro-Noya, Y.; Chávez-Romero, Y.; Hereira-Pacheco, S.; De León-Lorenzana, A.; Govaerts, B.; Verhulst, N.; Dendooven, L. Bacterial Communities in the Rhizosphere at Different Growth Stages of Maize Cultivated in Soil Under Conventional and Conservation Agricultural Practices. Microbiol. Spectr. 2022, 10, e0183421. [Google Scholar] [CrossRef]
- Oleńska, E.; Małek, W.; Wójcik, M.; Swiecicka, I.; Thijs, S.; Vangronsveld, J. Beneficial Features of Plant Growth-Promoting Rhizobacteria for Improving Plant Growth and Health in Challenging Conditions: A Methodical Review. Sci. Total Environ. 2020, 743, 140682. [Google Scholar] [CrossRef]
- Wan, Y.X.; Xu, W.H.; Hu, Y.L.; Li, Y.H.; Wang, Z.G. Screening and Identification of Maize Rhizosphere Growth-Promoting Bacteria and Evaluation of Their Growth-Promoting Effects. J. Maize Sci. 2024, 32, 144–153. [Google Scholar]
- Jha, V.; Purohit, H.; Dafale, N.A. Revealing the Potential of Klebsiella pneumoniae PVN-1 for Plant Beneficial Attributes by Genome Sequencing and Analysis. 3 Biotech 2021, 11, 473. [Google Scholar] [CrossRef]
- Liu, D.; Chen, L.; Zhu, X.; Wang, Y.; Xuan, Y.; Liu, X.; Chen, L.; Duan, Y. Klebsiella pneumoniae SnebYK Mediates Resistance Against Heterodera Glycines and Promotes Soybean Growth. Front. Microbiol. 2018, 9, 1134. [Google Scholar] [CrossRef] [PubMed]
- Liang, C.C.; Li, M.X.; Tan, D.D.; Huang, J.N.; Su, K.P.; Tan, Z.Y. Identification and Growth Promotion Characteristics of Endophytic Nitrogen Fixing Bacteria from Sedum Emarginatum. J. Hunan Ecol. Sci. 2024, 11, 18–25. [Google Scholar]
- Galperin, M.Y.; Kristensen, D.M.; Makarova, K.S.; Wolf, Y.I.; Koonin, E.V. Microbial Genome Analysis: The COG Approach. Brief. Bioinform. 2019, 20, 1063–1070. [Google Scholar] [CrossRef] [PubMed]
- Ni, S.; Wu, Y.; Zhu, N.; Leng, F.; Wang, Y. Bacillus licheniformis YB06: A Rhizosphere–Genome-Wide Analysis and Plant Growth-Promoting Analysis of a Plant Growth-Promoting Rhizobacterium Isolated from Codonopsis pilosula. Microorganisms 2024, 12, 1861. [Google Scholar] [CrossRef]
- Wang, X.Y. Development of New Bio-Organic-Chemical Slow-Release Fertilizer. Ph.D. Thesis, Shandong Agricultural University, Taian, China, 2020. China National Knowledge Infrastructure. Available online: https://kns.cnki.net/kcms2/article/abstract?v=ZscdH8NaPi9ebsFhTUYwkk9wbqcRJNsb7z5iDJSdMpS391Z-9xThHHp1gIyeM_KU6uZBauolzJSqfzuJhKnkFsFREj1VQ0LQLeO0OtKXuHkJxzU14d7MPhUZTy6qZjNHp71jUPOc7l0uoBiS-UZdVZU32aMBnRwAUTEb0F6WA_wMLy46qs0Kh_ayXqE9fp9g&uniplatform=NZKPT&language=CHS (accessed on 10 October 2020).
- NY/T 1109-2017; General Biosafety Standard for Microbial Fertilizers. China Agriculture Press: Beijing, China, 2018; pp. 1–13.
- Kumar, V.; Sarma, M.V.R.K.; Saharan, K.; Srivastava, R.; Kumar, L.; Sahai, V.; Bisaria, V.S.; Sharma, A.K. Effect of Formulated Root Endophytic Fungus Piriformospora Indica and Plant Growth-Promoting Rhizobacteria Fluorescent Pseudomonads R62 and R81 on Vigna Mungo. J. Biotechnol. 2011, 28, 595–603. [Google Scholar] [CrossRef]
- Fan, L.; Xue, Y.; Wu, D.; Xu, M.; Li, A.; Zhang, B.; Mo, J.; Zheng, M. Long-term nitrogen and phosphorus addition have stronger negative effects on microbial residual carbon in subsoils than topsoils in subtropical forests. Glob. Change Biol. 2024, 30, e17210. [Google Scholar] [CrossRef]
- Gao, P.; Ma, Y.Q.; He, Y.C.; Wang, B.X.; Ma, Y.H. Isolation, Identification and Growth-Promoting Ability of Azotobacter in Rhizosphere of Hippophae rhamnoides Subsp. Sinensis rousi. J. Fujian Agric. For. Univ. (Nat. Sci. Ed.) 2024, 53, 522–531. [Google Scholar]
- Li, Y.; Liu, X.; Hao, T.; Chen, S. Colonization and Maize Growth Promotion Induced by Phosphate Solubilizing Bacterial Isolates. Plant Growth Regul. 2017, 18, 1253. [Google Scholar] [CrossRef]
- Sun, X.; Shao, C.; Chen, L.; Jin, X.; Ni, H. Plant Growth-Promoting Effect of the Chitosanolytic Phosphate-Solubilizing Bacterium Burkholderia Gladioli MEL01 after Fermentation with Chitosan and Fertilization with Rock Phosphate. J. Plant Growth Regul. 2021, 40, 1674–1686. [Google Scholar] [CrossRef]
- Schalk, I.J. Bacterial Siderophores: Diversity, Uptake Pathways and Applications. Nat. Rev. Microbiol. 2024, 23, 24–40. [Google Scholar] [CrossRef]
- Bunsangiam, S.; Thongpae, N.; Limtong, S.; Srisuk, N. Large Scale Production of Indole-3-Acetic Acid and Evaluation of the Inhibitory Effect of Indole-3-Acetic Acid on Weed Growth. Sci. Rep. 2021, 11, 13094. [Google Scholar] [CrossRef]
- Zhang, T.; Wan, Y.X.; Xu, W.H.; Wang, Z.G.; Chen, W.J.; Hu, Y.L. Growth-Promoting Effects of a Rhizosphere Growth-Promoting Bacterium Leclercia adecarboxylata LN01 in Maize Plants and Its Whole-Genome Analysis. Biotechnol. Bull. 2025, 41, 263–275. [Google Scholar]
- Gupta, A.; Gopal, M.; Thomas, G.V.; Manikandan, V.; Gajewski, J.; Thomas, G.; Seshagiri, S.; Schuster, S.C.; Rajesh, P.; Gupta, R. Whole Genome Sequencing and Analysis of Plant Growth Promoting Bacteria Isolated from the Rhizosphere of Plantation Crops Coconut, Cocoa and Arecanut. PLoS ONE 2014, 9, e104259. [Google Scholar] [CrossRef] [PubMed]
- Liao, J.J.; Qin, Y.X.; Li, Z.J.; Zhu, S.L.; Li, F.Y.; Wu, G.F.; Li, X.M.; Pan, L.Q.; Liang, Y.Z.; Wei, L.T.; et al. Research Progress on Plant Rhizosphere Promoting Bacteria Relieving Abiotic and Biotic Stresses in Crops. Jiangsu Agric. Sci. 2025, 53, 9–15. [Google Scholar]
- Wang, J.W.; Tan, A.P.; Liu, J.L.; Tang, W.P.; Yi, J.M.; Guo, M.; Sun, B.W.; Sun, Z.R. Screening of Rhizosphere Growth-Promoting Bacteria of Desert Plants and Its Promoting Effects on Silage Maize Seedlings. Agric. Res. Arid Areas 2024, 42, 210–221. [Google Scholar]
- Lv, J.Y.; Gui, D.Y.; Zhang, Y.Y.; Li, R.; Chen, X.; Sha, Z.P. Field Application of Microbial Inoculants Improved Crop Foliar Morphology and Physiology Performance: A Global Meta-Analysis. Sci. Hortic. 2024, 326, 112769. [Google Scholar] [CrossRef]
- Li, G.; Shi, M.; Wan, W.; Wang, Z.; Ji, S.; Yang, F.; Jin, S.; Zhang, J. Maize Endophytic Plant Growth-Promoting Bacteria Peribacillus simplex Can Alleviate Plant Saline and Alkaline Stress. Int. J. Mol. Sci. 2024, 25, 10870. [Google Scholar] [CrossRef]
- Katsenios, N.; Andreou, V.; Sparangis, P.; Djordjevic, N.; Giannoglou, M.; Chanioti, S.; Kasimatis, C.-N.; Kakabouki, I.; Leonidakis, D.; Danalatos, N.; et al. Assessment of Plant Growth Promoting Bacteria Strains on Growth, Yield and Quality of Sweet Corn. Sci. Rep. 2022, 12, 11598. [Google Scholar] [CrossRef]
- Shi, J.-W.; Lu, L.-X.; Shi, H.-M.; Ye, J.-R. Effects of Plant Growth-Promoting Rhizobacteria on the Growth and Soil Microbial Community of Carya Illinoinensis. Curr. Microbiol. 2022, 79, 352. [Google Scholar] [CrossRef] [PubMed]
- Li, C.; Jia, Z.; Ma, S.; Liu, X.; Zhang, J.; Müller, C. Plant and Native Microorganisms Amplify the Positive Effects of Microbial Inoculant. Microorganisms 2023, 11, 570. [Google Scholar] [CrossRef] [PubMed]
- Rouphael, Y.; Colla, G. Toward a Sustainable Agriculture Through Plant Biostimulants: From Experimental Data to Practical Applications. Agronomy 2020, 10, 1461. [Google Scholar] [CrossRef]
- Baloch, N. Microbial Contributions to Maize Crop Production: A Comprehensive Review of Challenges and Future Perspectives. Discover Agric. 2025, 3, 10. [Google Scholar] [CrossRef]
- Nautiyal, C.S. An Efficient Microbiological Growth Medium for Screening Phosphate Solubilizing Microorganisms. FEMS Microbiol. Lett. 1999, 170, 265–270. [Google Scholar] [CrossRef]
- Eida, M.; Nagaoka, T.; Wasaki, J.; Kouno, K. Phytate Degradation by Fungi and Bacteria that Inhabit Sawdust and Coffee Residue Composts. Microbes Environ. 2012, 28, 71–80. [Google Scholar] [CrossRef]
- Zeng, Q.; Tang, L.; Zhang, Y.; Shao, Y.; Wu, W.; Wang, J.; Ding, X.; Han, X.; Muhammad, B. Isolation and Characterization of Phosphate-Solubilizing Bacteria from Rhizosphere of Poplar on Road Verge and Their Antagonistic Potential Against Various Phytopathogens. BMC Microbiol. 2023, 23, 221. [Google Scholar] [CrossRef]
- Kumari, S.; Vaishnav, A.; Jain, S.; Varma, A.; Choudhary, D.K. Bacterial-Mediated Induction of Systemic Tolerance to Salinity with Expression of Stress Alleviating Enzymes in Soybean (Glycine max L. Merrill). J. Plant Growth Regul. 2015, 34, 558–573. [Google Scholar] [CrossRef]
- Zhang, H.X.; Wang, Z.H.; Niu, B.; Guo, K.; Liu, L.; Jiang, Y.; Zhang, S.X. Screening, Identification and Broad-Spectrum Application of Efficient IAA-Producing Bacteria Dissolving Phosphorus and Potassium. Biotechnol. Bull. 2022, 38, 100–111. [Google Scholar]
- Glickmann, E.; Dessaux, Y. A Critical Examination of the Specificity of the Salkowski Reagent for Indolic Compounds Produced by Phytopathogenic Bacteria. Appl. Environ. Microbiol. 1995, 61, 793–796. [Google Scholar] [CrossRef]
- Yu, X.; Ai, C.; Xin, L.; Zhou, G. The Siderophore-Producing Bacterium, Bacillus Subtilis CAS15, Has a Biocontrol Effect on Fusarium Wilt and Promotes the Growth of Pepper. Eur. J. Soil Biol. 2011, 47, 138–145. [Google Scholar] [CrossRef]
- Schwyn, B.; Neilands, J.B. Universal CAS Assay for the Detection and Determination of Siderophores. Anal. Biochem. 1987, 160, 47–56. [Google Scholar] [CrossRef] [PubMed]
- Kang, S.M.; Wu, R.Y.; Mu, W.Q.; Shang, Q.M.; Li, P.L. Isolation and Biological Characteristics Investigation of Superior Plant Growth Promoting Rhizobacteria. J. China Agric. Univ. 2023, 28, 137–152. [Google Scholar]
- Holt, J.G.; Krieg, N.R.; Sneath, P.H.A.; Staley, J.T.; Williams, S.T. Bergey’s Manual of Determinative Bacteriology, 15th ed.; Williams & Wilkins: Baltimore, MD, USA, 1939; p. 408. [Google Scholar]
- Li, Z.H.; Wang, J.X.; Zhang, L.J.; Sun, Y.J.; Tian, R.; Yang, J.; Liu, J. Whole Genome Sequencing and Comparative Genomic Analysis of Streptomyces sp. YH02 Isolated from the Soil Sediment in Yuncheng Salt Lake. Acta Microbiol. Sin. 2025, 65, 1053–1069. [Google Scholar]
- Thompson, C.C.; Chimetto, L.; Edwards, R.A.; Swings, J.; Stackebrandt, E.; Thompson, F.L. Microbial Genomic Taxonomy. BMC Genom. 2013, 14, 913. [Google Scholar] [CrossRef] [PubMed]
- Zhang, H.B. Study on Ecological Adaptability for Maize Varietiy of Zhengdan 958 in Spring Maize Area of Northeast China. Ph.D. Thesis, Shandong Agricultural University, Taian, China, 2009. China National Knowledge Infrastructure. Available online: https://kns.cnki.net/kcms2/article/abstract?v=ZscdH8NaPi9W_wL_KErYjZbe5p6ZsgI0gubQiJ5IUIiHfA653JAvTPPgethGSbHSTx-QAEu_TuiHOduNEDJCel7-zWNakK9vV_2f5ryYSM6WDkZ3GVnEvPH5eFyuRvxcLlOSm4vWrN1MY6iYrJiTEIsZU3xFqvtWfnjTFH3K8lBzG2_-5JTiIw==&uniplatform=NZKPT&language=CHS (accessed on 7 June 2009).
- Bao, S.D. Soil Agrochemical Analysis, 3rd ed.; China Agriculture Press: Beijing, China, 2000. [Google Scholar]
- Zeng, Z.Q.; Li, X.; Li, P. Study on Conditions Optimization of Determination of Iron Content by Phenanthroline Color Method. Guangzhou Chem. Ind. 2018, 46, 77–80. [Google Scholar]

| Identification Items | Strain YMK25 | Identification Items | Strain YMK25 |
|---|---|---|---|
| Methyl red reaction | − | Arginase utilization | − |
| Voges–Proskauer (VP) | + | Lysine decarboxylase utilization | + |
| Glucose fermentation test | + | Ornithine decarboxylase utilization | − |
| Lactose fermentation test | + | Gelatin hydrolysis | − |
| Citrate utilization | + | Hydrogen sulfide (H2S) | − |
| Malonate utilization | + | Urease utilization | + |
| Features | 1 | 2 | 3 | 4 | 5 |
|---|---|---|---|---|---|
| Total length of the genome (bp) | 5,115,280 | 5,545,784 | 5,465,736 | 5,442,219 | 5,280,350 |
| G+C content (%) | 57.61 | 57 | 58 | 57.4 | 54.8 |
| CDS (number) | 4746 | 5162 | 5045 | 5037 | 4874 |
| tRNA (number) | 79 | 77 | 71 | 75 | 84 |
| PGPR Traits | Pathway |
|---|---|
| IAA | trpA trpB trpCF trpE trpD trpR trpS trpGD ipdC patB aldh |
| Siderophore | tonB exbB entA entA entC entE fhuB fhuC fhuD fhuF efeB efeO efeU fepA fepB fepC fepG afuA afuB afuC sitB sitC sitD |
| Nitrogen generation | nirB nirD nasB nasC nifj nrtA nrtB nrtC ureA ureB ureC glnA glnB gltA gltB gltD narL narH |
| Phosphate solubilization | phoA phoB phoE phoR phoH pstA pstB pstC pstS phnA phnB phnC phnD phnE phnF phnG phnH phnI phnJ phnK phnM phnN |
Disclaimer/Publisher’s Note: The statements, opinions and data contained in all publications are solely those of the individual author(s) and contributor(s) and not of MDPI and/or the editor(s). MDPI and/or the editor(s) disclaim responsibility for any injury to people or property resulting from any ideas, methods, instructions or products referred to in the content. |
© 2025 by the authors. Licensee MDPI, Basel, Switzerland. This article is an open access article distributed under the terms and conditions of the Creative Commons Attribution (CC BY) license (https://creativecommons.org/licenses/by/4.0/).
Share and Cite
Yu, X.; Xia, J.; Bi, S.; Wang, H.; Zhao, C. Whole-Genome Analysis and Growth-Promoting Mechanism of Klebsiella pneumoniae YMK25 from Maize Rhizobacteria. Plants 2025, 14, 2738. https://doi.org/10.3390/plants14172738
Yu X, Xia J, Bi S, Wang H, Zhao C. Whole-Genome Analysis and Growth-Promoting Mechanism of Klebsiella pneumoniae YMK25 from Maize Rhizobacteria. Plants. 2025; 14(17):2738. https://doi.org/10.3390/plants14172738
Chicago/Turabian StyleYu, Xinhui, Jinnan Xia, Shaojie Bi, Haipeng Wang, and Changjiang Zhao. 2025. "Whole-Genome Analysis and Growth-Promoting Mechanism of Klebsiella pneumoniae YMK25 from Maize Rhizobacteria" Plants 14, no. 17: 2738. https://doi.org/10.3390/plants14172738
APA StyleYu, X., Xia, J., Bi, S., Wang, H., & Zhao, C. (2025). Whole-Genome Analysis and Growth-Promoting Mechanism of Klebsiella pneumoniae YMK25 from Maize Rhizobacteria. Plants, 14(17), 2738. https://doi.org/10.3390/plants14172738

